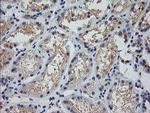
MDM4 Antibody in Immunohistochemistry (Paraffin) (IHC (P))

Search
OriGene
MDM4 Monoclonal Antibody (OTI2E11), TrueMAB™
{{$productOrderCtrl.translations['antibody.pdp.commerceCard.promotion.promotions']}}
{{$productOrderCtrl.translations['antibody.pdp.commerceCard.promotion.viewpromo']}}
{{$productOrderCtrl.translations['antibody.pdp.commerceCard.promotion.promocode']}}: {{promo.promoCode}} {{promo.promoTitle}} {{promo.promoDescription}}. {{$productOrderCtrl.translations['antibody.pdp.commerceCard.promotion.learnmore']}}
产品信息
TA505749
种属反应
宿主/亚型
分类
类型
克隆号
抗原
偶联物
形式
浓度
纯化类型
保存液
内含物
保存条件
运输条件
靶标信息
The MDM2 protein is the primary regulator of p53 protein stability. MDMX is an MDM2-related protein that inhibits MDM2-mediated degradation of p53 via distinct associations with MDM2. The gene that encodes MDMX (also designated MDM4) is a target for amplification in malignant gliomas. ARF interacts with MDMX to sequester MDMX within the nucleolus. This sequestration of MDMX by ARF results in an increase in p53 transactivation. In addition, expression of MDMX can reverse MDM2-targeted degradation of p53 while maintaining suppression of p53 transactivation. Like MDM2, MDMX also binds p73 and stabilizes the level of p73. Therefore, in striking contrast to p53, the half-life of p73 is increased by binding to MDM2.
仅用于科研。不用于诊断过程。未经明确授权不得转售。
篇参考文献 (0)
生物信息学
蛋白别名: DKFZp781B1423; Double minute 4 protein; double minute 4, human homolog of; p53-binding protein; human homolog of; Mdm2-like p53-binding protein; Mdm4 p53 binding protein homolog; MDM4 protein variant G; MDM4 protein variant Y; MDM4-related protein 1; MGC132766; p53-binding protein Mdm4; Protein Mdm4; Protein Mdmx; RP11-430C7.1
基因别名: HDMX; MDM4; MDMX; MRP1
UniProt ID: (Human) O15151
Entrez Gene ID: (Human) 4194